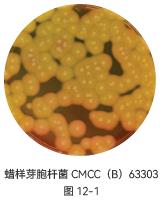

- 首页
-
产品
- 微生物
- 生命科学工具
- Oligo合成
- 过滤耗材
- Spinflow® 微孔过滤
-
核酸纯化
-
核酸提取纯化柱
- biocomma® RNA提取柱
- 超微量DNA产物纯化柱
- CommaPure® Resin法质粒超大提柱
- biocomma® DNA产物纯化及凝胶回收柱
- biocomma® 大体积微提柱
- biocomma® 微量样品基因组提取柱
- biocomma® 基因组提取柱
- CommaPure® Resin法质粒大提柱
- biocomma® 质粒大体积小提中量柱
- biocomma® 质粒小提中量柱
- biocomma® 质粒大提柱
- biocomma® 质粒中提柱
- biocomma® 质粒小提柱
- CommaX™ 核酸纯化柱,0-100ug
- CommaX™ 核酸纯化柱,0-30ug
- CommaX™ 核酸纯化柱,0-10ug
- CommaX™ 核酸纯化柱,0-20ug
- 核酸提取纯化板
- 菌液过滤柱
- 菌液过滤板
- 核酸纯化柱(阴离子交换法)
- CommaTip® 核酸提取吸头
- 蛋白酶 K
- 硅胶膜
- 异硫氰酸胍(分子生物级)
-
核酸提取纯化柱
- 工程菌培养基
- 无菌液体试剂
- 通用试剂
- 通用耗材
- 色谱质谱
- Copure® Pro高通量解决方案
-
色谱柱
-
CommaSil® 液相色谱柱
- CommaSil® C18 通用型液相色谱柱
- CommaSil® C18-T杂化硅胶液相色谱柱
- CommaSil® C18-P 100%耐纯水液相色谱柱
- CommaSil® T3-H 三键键合液相色谱柱
- CommaSil® C8液相色谱柱
- CommaSil® C4 300 Å液相色谱柱
- CommaSil® Phenyl 色谱柱
- CommaSil® Phenyl Hexyl液相色谱柱
- CommaSil® PFP 色谱柱
- CommaSil® Silica液相色谱柱
- CommaSil® NH2液相色谱柱
- CommaSil® CN 液相色谱柱
- CommaSil® 糖专用HPLC柱
- CommaSil® 防腐剂专用HPLC柱
- CommaSil® 保护柱
- Copure® 系列色谱柱
-
CommaSil® 液相色谱柱
- SPE柱
- Copure® QuEChERS
- 真菌毒素
- 生物样本前处理
- 设备/耗材
- 填料
- Silibase® 品牌产品
- 过滤
- 医疗
- 慧养
- 解决方案
- 定制及OEM制造服务
- 资源中心
- 工程研究中心
- 实力工厂
- 关于逗点